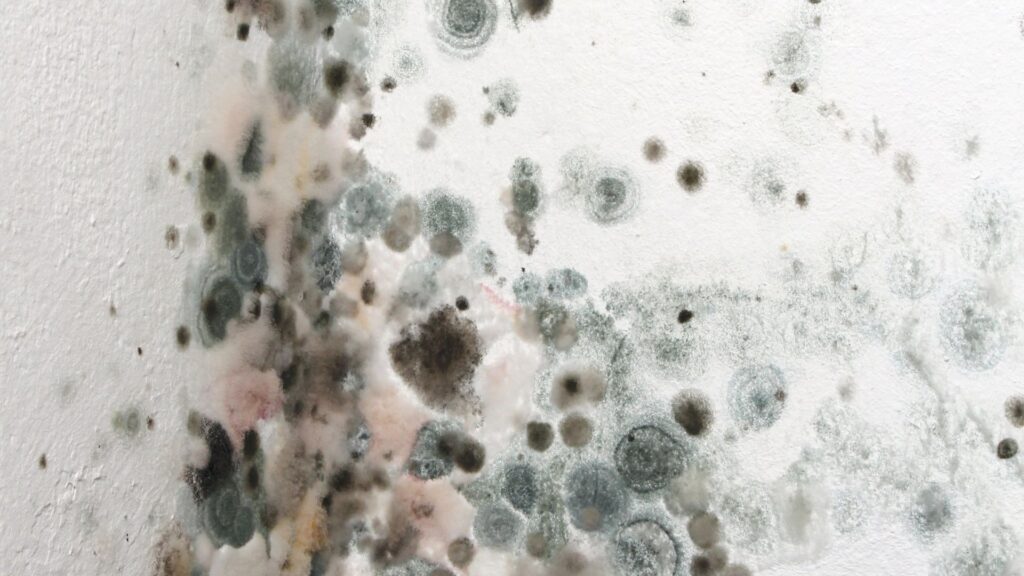

Posts by madwire
A Simple Guide to How Acupuncture Calms Your Nervous System
If you feel like your body is stuck in a constant state of “fight-or-flight,” you aren’t alone. Modern stress can keep your nervous system on high alert, leading to exhaustion and chronic pain. At Arne Wellness Center, we use acupuncture to help you flip the switch from stress to relaxation, restoring your natural internal balance.…
Read MoreIs Your Desk Job Aging Your Spine? Understanding and Treating Cervical Strain
The modern workday often demands hours of static sitting, but your spine pays the price. At Arne Wellness Center, we see how prolonged desk work leads to cervical strain, effectively “aging” your neck prematurely. Understanding these physical tolls is the first step toward reclaiming your health and maintaining a youthful, pain-free range of motion. The…
Read MoreThe Great Imitator: Why Lyme Disease is Often Misdiagnosed as Fibromyalgia or Chronic Fatigue
Are you struggling with persistent exhaustion or widespread pain that defies explanation? Many patients arriving at Arne Wellness Center, serving Littleton, CO, have been previously told they have fibromyalgia or chronic fatigue syndrome. However, these symptoms often mask a hidden culprit: Lyme disease. Understanding why this “Great Imitator” is so frequently misidentified is the first…
Read MoreTreating Lyme Disease: Why EBOO Is a Game Changer for Chronic Cases
Chronic Lyme disease is a thief; it steals your energy, your mental clarity, and your physical comfort. For many patients, standard treatments fail to address the lingering pathogens that hide deep within the body. At Arne Wellness Center, we are proud to offer EBOO — the most advanced form of ozone therapy available — to…
Read MorePost-Viral Recovery: Can IV Ozone Help You Bounce Back Faster?
Recovering from a viral illness often feels like an uphill battle. Even after the acute symptoms fade, fatigue and brain fog can linger for weeks or even months. If you are struggling to return to your normal self, you aren’t alone. At Arne Wellness Center, we specialize in advanced therapies designed to support your body’s…
Read MoreMold Toxicity and Brain Fog: Clearing the Haze with Advanced Ozone Therapy
Do you feel like you are constantly looking through a dirty window, unable to think clearly or focus? Mold toxicity is a pervasive issue that often goes undiagnosed, and its connection to cognitive decline is significant. We understand how frustrating it is to battle unexplained fatigue and confusion. Understanding the Mold-Brain Connection Mold toxicity often…
Read MoreBoosting Immunity in a Dry Climate: The Vitamin C IV Shield
Living in Colorado means battling constant dryness, which strains your immune defenses. Your mucous membranes dry out, making it easier for viruses to enter. While drinking water helps, it is often not enough to combat the arid environment. You need a more direct approach to stay protected and hydrated year-round. Learn more about our IV…
Read MoreAre You a Candidate for EBOO? Who Benefits Most from Advanced Blood Filtration
If you have struggled with chronic health issues that standard treatments fail to resolve, you might feel stuck. Often, the root cause lies deep within the bloodstream, where toxins and inflammation accumulate. For many patients, standard ozone treatment is beneficial, but Extracorporeal Blood Oxygenation and Ozonation (EBOO) offers a more profound level of systemic cleansing…
Read MoreStop the Slump: Why IV Hydration is Your Essential Wellness Reset
The subtle toll of dehydration is often mistaken for general fatigue or an inevitable afternoon slump. At Arne Wellness Center, we recognize that many people are walking around chronically under-hydrated, which affects everything from energy levels to cognitive function. While drinking water helps, it can take time to rebalance your system effectively. We offer IV…
Read More